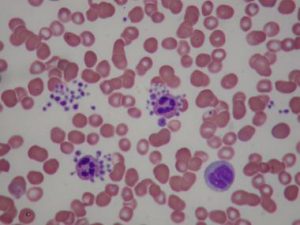

This is a rare inherited bleeding disorder resulting in the abnormal platelets that have a gray appearance under the light microscope. The platelets are essential cells that circulate in the blood and stop bleeding during an injury. This disorder is the result of absence or reduction of alpha-granules in platelets that give them the adhesive quality as well as wound healing feature when an injury occurs. Gray platelet syndrome affects the newborn infant but may not be discovered until early childhood. Globally there is only 60 recorded case of this syndrome. This is inherited in an autosomal recessive manner where both the copies of the defect gene are present in each cell. The means the parents each carry the mutated gene and pass it to their child. Gray platelet syndrome is also inherited in an autosomal dominant pattern where one copy of the mutated gene is responsible for the disorder when one parent carries the defect gene. This syndrome is also known as deficient alpha granule syndrome and platelet granule defect.
Causes
Gray platelet syndrome is associated with the mutation of the gene NBEAL2. This mutation affects the production of alpha-granules within the platelets which are normally produced during an injury. These granules have the adhesive quality that is essential for blood clotting and wound healing. The defect in its production results in larger and fewer platelets. The deficit of alpha-granules tends to impair the normal functions of the platelets resulting in abnormal bleeding. These affected platelets give the gray appearance when observed under the microscope.
Symptoms
The bone marrow is responsible for the production of the blood cells for the body. The individuals develop an accumulation of the scar tissues (myelofibrosis) in the bone marrow that may affect the blood production. As a result of low blood, spleen produces blood cells causing enlarged spleen (splenomegaly). Individuals with this syndrome are vulnerable to excessive bleeding after an injury, may bruise easily, at risk of nosebleed and heavy menstrual bleeds in women.
Diagnosis and Treatment
Diagnosis for Gray platelet syndrome may involve blood analysis to assess the platelet count, alpha-granule examination and bone marrow biopsy.
Treatment usually involves the management measure to prevent bleeding. Platelet transfusion may be performed prior to a surgery and medications to advance the clotting time. In some cases, surgical removal of the spleen may be necessary to improve platelet count increase. The individuals with the platelet count lower than 30,000/micro liter are at higher risk of life-threatening bleeding conditions.